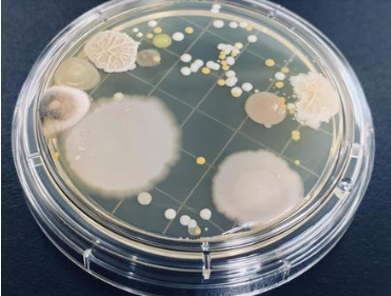
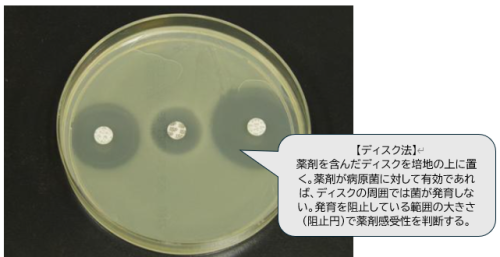

細菌・ウィルス検査
いつもご覧いただきありがとうございます。
検査シリーズとしていくつかの検査に分けて紹介していきます。
シリーズ1は、血液検査についてご紹介いたしました。
シリーズ2では、細菌・ウィルス検査について触れていきます。
実習、臨床での参考にしていただければ幸いです。

お急ぎの方は以下の項目からスキップしてください。
Ⅰ.細菌・ウィルス検査をする目的
1)病原体(細菌・真菌・ウィルス・原虫など)を特定する。
この後に紹介する方法によって、症状を起こしている感染源を特定する。
2)病原体(細菌・真菌・ウィルス・原虫など)に効果のある薬剤を特定する。
細菌には薬剤に対する耐性を持っているものがある。
耐性菌に対して効果のある抗生剤を特定する検査がある。
それを「薬剤感受性試験」といいます。
Ⅱ.検査による病原体の特定
検体の採取から提出までの概要は以下の通り。
①指示された病原菌(検体)を採取する。
採取の際はスタンダードプリコーションをして、清潔な状態で行う。
本来無菌である場所からの検体採取は特に注意を払い、
コンタミネーションを防いで適切に検体を採取しましょう。
②検体を滅菌の容器などの指定の容器に入れて検査室へ提出する。
Ⅲ.検体の種類
・呼吸器系:喀痰、咽頭ぬぐい(粘液)、鼻腔ぬぐい(粘液)、気管支擦過物
気管支肺胞洗浄液
・消化器系:便、胆汁
・泌尿器系:尿、尿管カテーテル先端、膣分泌物、前立腺分泌物
・血液:血液
・穿刺液:髄液、胸水、腹水、関節液、CVカテーテル先端
・その他:耳漏、褥瘡、組織、皮膚、爪、膿
お急ぎの方は以下の項目からスキップしてください。
Ⅳ.各検査の概要と特徴
細菌検査には以下の5つの方法があります。
①塗抹染色検査
②培養同定検査
③PCR検査(ポリメラーゼ連鎖反応)
④抗原直接検出法
⑤抗原検出法
①塗抹染色検査

検体をスライドガラスに塗抹し染色する。顕微鏡で細菌の有無と菌の量を特定する検査。
最も早く、簡便に菌の存在を把握できる検査。
塗抹染色検査では死菌も陽性となる。
染色方法は以下の通り
「グラム染色」ブドウ球菌、肺炎球菌、レンサ球菌、腸球菌、カンジダ、クロストリジウム、
クリプトコッカス、淋菌、髄膜炎菌、インフルエンザ菌、カンピロバクター、ピロリ菌
「チール・ネルゼン染色」「蛍光(オーラミン)染色」結核菌、非結核抗酸菌
「墨汁染色」クリプトコッカス
「KOH染色」真菌
②培養同定検査
検体を培地で培養して増やし、菌種を特定する検査。
生きている菌のみが増殖するため、感染源の特定には最も有効だが、培養検査は判定までに時間がかかる2~4週間。
培地には「液体」と「固体」がある。
A:液体培地
細菌や酵母を培養して増殖できる。
B:固形培地
プレートに移すことでコロニーを形成させ、病原体を特定できる。
培養させたい目標の菌によって培地を変える。培地の種類は以下の通り。
・単純・基本培地:ブイヨンやペプトン水を含む培地で、各種細菌の単離や培養に使用される
・複合培地:各種栄養成分の混合物を含む培地で、チョコレート寒天、マッコンキー寒天
などがある。
・規定培地:特定の細菌に必要な炭素と窒素を含ませた培地
・特殊培地:難しい細菌の増殖を促進し、標的以外の細菌の増殖を抑える特殊物質を含む培地。
③PCR検査(ポリメラーゼ連鎖反応)

PCRは、特定のDNA断片を増幅するために使用されます。例えば、病原体のDNAや遺伝子の増幅、DNAのクローニング、遺伝子型の解析などに利用される。
PCRはDNAポリメラーゼ酵素を用いて、DNA断片を特定のプライマー(オリゴヌクレオチド)で増幅する。反応は熱サイクルで行われ、DNA断片が指数的に増加する。PCRはDNA断片を増幅する技術。
培養できない微生物や成長の遅い微生物の道程も可能となる。
死んでいる菌でも陽性となる。
④抗原直接検出法
・蛍光抗体法:蛍光色素で標識した抗体と反応させて、抗原を視覚化する方法。
・酵素抗体法:酵素で標識した抗体と反応させて、抗原を視覚化する方法。
・ラテックス凝集法:ラテックス粒子という粒子に抗体を固相(貼り付け)し、
抗原とラテックス粒子を反応させて視覚化する方法。
・DNAプローブ法:DNAプローブ法は、特定のDNAまたはRNAを検出するために使用される。
PCRと似ているが、PCRはDNA断片の増幅ができる技術で、DNAプローブ法は
特定のDNAまたはRNAの検出ができる技術。
⑤抗原検出法

・迅速同定キット:病原体の材料から直接検出ができるキット。感染の流行や、感染者との接触などで、疑わしい病原体が限定されるときにはこのキットを使えば迅速に診断できる。
お急ぎの方は以下の項目からスキップしてください。
Ⅴ.検査で調べられる病原体
①塗抹染色検査
★グラム染色法:
・グラム陽性(紫色または青紫色に染まる)
・球菌:肺炎球菌、レンサ球菌、腸球菌、ブドウ球菌
・杆菌:結核菌、らい菌、セレウス菌、ジフテリア菌、炭疽菌、枯草菌、納豆菌
・その他:真菌も陽性の色に染まる
・グラム陰性(赤色または桃色に染まる)
・球菌:淋菌、髄膜炎菌
・桿菌:緑膿菌、腸内細菌(大腸菌、サルモネラ菌、ペスト菌など)、
百日咳菌、インフルエンザ菌
・らせん状杆菌;ヘリコバクターピロリ、コレラ菌、ビブリオ菌
カンピロバクター、梅毒トレポネーマ
・その他:マイコプラズマ、原虫、白血球、クラミジア、リケッチア
★墨汁染色法:クリプトコッカス
★KOH染色法:真菌
★「チール・ネルゼン染色」「蛍光(オーラミン)染色」結核菌、非結核抗酸菌
②培養検査
A:液体培地
細菌や酵母を培養して増殖できる。
・大腸菌
・肺炎球菌
・乳酸菌
B:固形培地
プレートに移すことでコロニーを形成させ、病原体を特定できる。
培養させたい目標の菌によって培地を変える。
・単純・基本培地:各種細菌の単離や培養
・複合培地:
・チョコレート寒天(血液を含む培地):インフルエンザ菌
・マッコンキー寒天(ラクトースを含む培地):大腸菌などの腸内細菌
・SS寒天培地:サルモネラ菌、赤痢菌など便からの分離
・TCBS培地:ビブリオ属の選択分離培地
・規定培地:特定の細菌に必要な炭素と窒素を含ませた培地
・LB培地:大腸菌の培養
・特殊培地:難しい細菌の増殖を促進し、標的以外の細菌の増殖を抑える特殊物質を含む培地。
・マッコンキー寒天(ラクトースを含む培地):大腸菌などの腸内細菌
・TCBS培地:ビブリオ属の選択分離培地
③PCR検査(ポリメラーゼ連鎖反応)
・B型肝炎
・C型肝炎
・ヒトパピローマウイルス(子宮頸がん)
・ヒト免疫不全ウィルス(HIV)
・単純ヘルペスウィルス
・クラミジア・トラコマチス
・淋菌
・インフルエンザ
・結核菌
・非結核性抗酸菌
・SARS-CoV-2(新型コロナウィルス)
・サイトメガロウィルス
④抗原直接検出法
⑤抗原検出法
【迅速同定キット】
・SARS-CoV-2(新型コロナウィルス)
・インフルエンザ
・A.B溶連菌
・肺炎球菌
・大腸菌O-157
・レジオネラ
・アデノウィルス
・クロストリジウムディフィシル
・マイコプラズマ
・ヘリコバクター・ピロリ
・B型肝炎
・ヘルペスウィルス
・水痘帯状疱疹ウィルス
・ノロウィルス
・ロタウィルス
Ⅵ.薬剤感受性検査
薬剤感受性検査は、検出された病原体に対する抗菌薬の効能を定量的に調べる検査。
抗菌薬を培養液に加えたものを抗菌薬の数だけ準備し、そこに病原菌を添加して培養する。その後、菌の発育状況をみて 、一定濃度以下であれば効果ありで「感受性」と判断され、一定濃度より多ければ薬剤にたいしての耐性を持つ「非感受性」と判断する。
「ディスク法」「濃度勾配ストリップ法」「微量液体希釈法」がある。
Ⅶ.薬剤耐性菌
① MRSA(メチシリン耐性黄色ブドウ球菌)
メシチリン(ペニシリン系)、アミノグリコシド系、マクロライド系に耐性を示す黄色ブドウ球菌。
院内感染に多いが市中感染もある。
治療は、バンコマイシン、タゴシッド、ザイボックス、ハベカシンで行う。
② 薬剤耐性緑膿菌
緑膿菌は健常者には病原性が弱く、感染症を起こしにくいが、感染症を発症すると難治となる。術後感染症などの日和見感染症の起炎菌として問題となる。
第一世代セフェム系に自然耐性がある。テトラサイクリン系やマクロライド系でも耐性を示す傾向。
緑膿菌は耐性を持ちやすい菌。
治療は以下の抗生剤を使用する。
・広域抗菌薬
ペニシリン系:ペントシリン(PIPC)やゾシン(PIPC/TAZ)
セフェム系:モダシン(CAZ)やマキシピーム(CFPM)、ファーストシン(CZOP)
カルバペネム系:チエナム(IPM/CS)、メロペン(MEPM)、フィニバックス(DRPM)
ニューキノロン系:シプロキサン(CPFX)、クラビット(LVFX)
アミノグリコシド系:ゲンタシン(GM)、アミカシン(AMK)、トブラシン(TOB)
近年は、カルバペネム系、アミノ配糖体系、フルオロキノロン系の3系統の薬剤に対して耐性を示す緑膿菌も出てきており、多剤耐性緑膿菌と呼ばれている。
③ PRSP(ペニシリン耐性肺炎球菌)
ペニシリンGに対して耐性を示す肺炎球菌(市中感染がほとんど)。
肺炎、中耳炎、髄膜炎などをひき起こす細菌。
治療は、カルバペネムやペニシリンの大量投与を行う。重症例ではカルバペネムとグリコペプタイドの併用療法も。成人にはニューキノロン投与も有効。
高齢や免疫抑制状態のハイリスク患者には肺炎球菌ワクチン(ニューモバックス)が認可されている。
④ VRE(バンコマイシン耐性腸球菌)
バンコマイシンに対して耐性を示す腸球菌で、バンコマイシン以外の抗生剤にも耐性を持つため、治療が困難である。健常者には病原性が弱くほとんど無害。
術後の感染、免疫力低下時の日和見感染に注意が必要。
治療は以下の抗生剤を使用する。
・オキサゾリジノン系:リネドリド(ザイボックス)
・ストレプトグラミン計:キヌプリスチン・ダルホプリスチン(シナシッド)
⑤ 薬剤耐性アシネトバクター
βラクタム系、アミノ配糖体系、フルオロキノロン系の3系統の薬剤に対して耐性を示す細菌。
アシネトバクターは常在菌で腋窩、股間、趾間に存在している。健常者には病原性を示さないが、免疫力低下時には注意が必要。肺炎、尿路感染、手術部位感染、外傷部位感染、カテーテル関連血流感染、敗血症の原因となる。
治療は以下の抗生剤を使用する。
・カルバペネム系
・スルバクタム
・第3世代セフェム、第4世代セフェム
・ミノサイクリン
最期までお付き合いいただきありがとうございました。
参照文献
野中廣志. (2008.6.15). 看護に役立つ検査辞典. 株式会社 照林社.
参照ホームページ
一般社団法人 日本衛生検査所協会「細菌検査 塗抹・培養 ガイドライン 第2版」
https://www.jrcla.or.jp/origin/wp-content/uploads/2023/06/%E7%B4%B0%E8%8F%8C%E6%A4%9C%E6%9F%BB-%E5%A1%97%E6%8A%B9%E3%83%BB%E5%9F%B9%E9%A4%8A%E3%82%AC%E3%82%A4%E3%83%88%E3%83%A9%E3%82%A4%E3%83%B3.pdf
Wikipedia「ポリメラーゼ連鎖反応」
https://ja.wikipedia.org/wiki/%E3%83%9D%E3%83%AA%E3%83%A1%E3%83%A9%E3%83%BC%E3%82%BC%E9%80%A3%E9%8E%96%E5%8F%8D%E5%BF%9C
Wikipedia「グラム染色」
https://ja.wikipedia.org/wiki/%E3%82%B0%E3%83%A9%E3%83%A0%E6%9F%93%E8%89%B2
Wikipedia「培地」
https://ja.wikipedia.org/wiki/%E5%9F%B9%E5%9C%B0
Wikipedia「寒天培地」
https://ja.wikipedia.org/wiki/%E5%AF%92%E5%A4%A9%E5%9F%B9%E5%9C%B0
Wikipedia「薬剤耐性」
https://ja.wikipedia.org/wiki/%E8%96%AC%E5%89%A4%E8%80%90%E6%80%A7
株式会社ミズホメディー 「製品情報」 ※迅速キット
https://www.mizuho-m.co.jp/product/product_index.html



“細菌・ウィルス検査” に対して4件のコメントがあります。